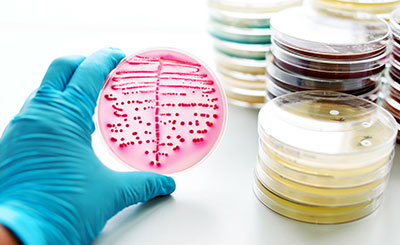

我们的服务项目
-


配方研发
-


工业诊断
-


产品检测
-


成分分析
-


未知物分析
-


在线咨询

配方研发
包含配方分析、配方解析、配方研发、性能改进、还原产品配方等。
配方分析,通过对样品进行成分分析,提供样品基本配方并为客户推荐原材料及工艺。
微谱拥有强大的仪器平台和数据库,经验丰富的专业技术团队,通过光谱、色谱、核磁等精密仪器分析样品成分的化学名称和成分含量,还原产品配方。
咨询工程师 GO
工业诊断
包含杂质/副产物分析、原材料质控/评价、材料成分一致性评价等
产品不合格时,可通过微谱分析,确定问题是配方还是杂质原因,最终指定解决方案。
对原材料成分、纯度等进行测试,评价原材料的纯度是否符合要求、性能是否达标等,对某些高纯原料的杂质、或某些化学反应的副产物进行分析确定其成分及含量,其分析结果可作为评价高纯原料、优化化学反应的重要依据。
咨询工程师 GO
产品检测
理化性能检测、有毒有害物质检测、产品评估方法开发等
借助微谱大型仪器,对切削液产品有害物质检测,理化指标检测,重点检测项目:含量、杂质元素、粒度、白度、色度、灰分、酸度、碱度、水分、折光率、密度、粘度、熔点、沸点、挥发分、软化点、结晶温度、不溶物、pH值、吸碘值、吸油值、孔容孔径、比表面积等,力求为客户提供产品质量数据,排查产品性能是否达标。
咨询工程师 GO
成分分析
成分分析、成分列表分析、指定成分分析、定性定量分析等
微谱拥有大型精密仪器,实验室获资质并荣获高新技术企业等荣誉称号。
作为切削液专业分析机构,由经验丰富且领域细分的分析工程师,通过多种大型分析仪器联合使用,对切削液进行分析达到客户需求。
咨询工程师 GO
未知物分析
异物分析、失效分析、未知物分析等
通过微谱分析,对生产/运输/使用等过程中出现的异物进行定性或定量测试,提供异物分析报告。
对产品失效原因、未知物成分的组成、分子结构进行深入剖析,分析结果可以辅助判断未知物产生的根源及问题所在。
咨询工程师 GO关于我们

微谱,大型研究型检测机构,始于2008年,总部位于上海,是科技服务改变世界的践行者
微谱聚焦先进制造、生物医药、美丽健康、生态环境、食品农产品五大领域,向社会提供分析测试、检测评价、研发服务、计量校准、认证审核、知识产权六大服务,全方位的技术解决方案助力客户取得更大成功。
微谱现已在全国30多个城市设立分子公司以及60多个专业实验室,拥有3000余名专业人员。
微谱始终秉承“服务,不止于检测!”的理念,尽心尽力让科技进步更快,让产品质量更好,让人类生活更安全、更健康、更绿色!
微谱拥有强大的仪器平台和数据库,10余年行业经验的技术团队
-

热分析/红外分析实验室
-

气相实验室
-

理化分析实验室
-

扫描电镜实验室
-

色谱实验室

 高分子领域
高分子领域 精细化学品
精细化学品 化妆及消毒品
化妆及消毒品 环境检测
环境检测 生物医药
生物医药 金属领域
金属领域 食品领域
食品领域 热门行业
热门行业 我们的服务
我们的服务

























